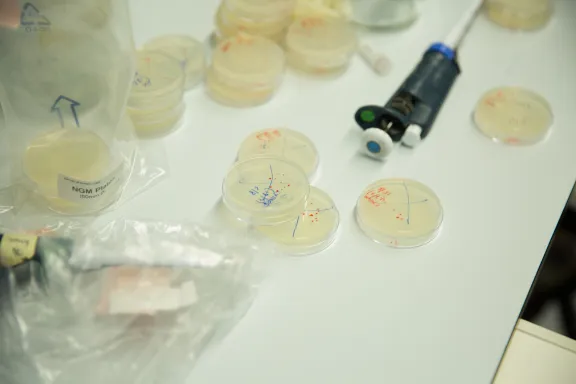

Benjamin Lehner Beyond the sequence: predict inter-individual variations
Benjamin Lehner, professor at the Catalan Institution for Research and Advanced Studies, head of the Genetic Systems team at the Center for Genomic Regulation, Barcelona (Spain)
- 2016 • Liliane Bettencourt Prize for Life Sciences


©DR
With his team at the Centre for Genomic Regulation in Barcelona, Ben Lehner combines genetic exploration with research into cancer through large-scale experiments, using bioinformatics methods. These approaches enable him to better understand how genetic sequencing results in characteristics that are unique to each individual. Some people carry a deleterious mutation in their genome without ever developing the associated disease.
How can differences in observable characteristics – or phenotype – between individuals be foreseen by sequencing their genomes? Ben Lehner carries out research into highly fundamental questions regarding the complexity of genetic interactions in yeast and the simple Caenorhabditis elegans worm. He uses the power of genetic databases to draw conclusions on human biology. He has for example performed pioneering work on genetic interactions naturally present in all organisms. The combined mutations of two genes reveal surprising phenotypes and even death. Pairs of partner genes are not necessarily expressed in all individuals, making it difficult to predict phenotype on the basis of a simple sequence.
Supported by the Foundation, this British scientist is set to investigate the origins of these variations in Caenorhabditis elegans. The small size and rapid growth of this worm enable high numbers of conditions to be tested. When transferred to humans, the results of this research will enable the interaction partners of numerous mutations of cancer cells to be specically targeted, leading to the development of personalised therapies. Indeed, predictive and personalised medicine as a whole will benefit from this new understanding of interactions between genomes, the environment, personal history, parental history and chance.
Liliane Bettencourt Prize for Life Sciences
The Liliane Bettencourt Prize for Life Sciences rewards each year a researcher under the age of 45 for the excellence of their work and their remarkable contribution to their field of scientific research. This prize is awarded, depending on the year, to a researcher based in France or working in another European country. Thirty winners have been awarded since 1997. From 2023, prize rewards the laureate up to 100,000 euros.
All the award-winners


